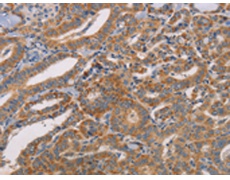
一抗

中文名稱:兔抗CDK11A/CDK11B多克隆抗體
英文名稱: Anti-CDK11A/CDK11B rabbit polyclonal antibody
別 名: CDC2L2; CDC2L3; p58GTA; PITSLRE; CDK11-p46; CDK11-p58; CDK11-p110 / p58; PK58; CDK11; CLK-1; CDC2L1; p58CLK-1; CDK11-p46; CDK11-p58;
相關(guān)類別: 一抗
儲 存: 冷凍(-20℃)
宿 主: Rabbit
抗 原: CDK11A/CDK11B
反應(yīng)種屬: Human, Mouse
標 記 物: Unconjugate
克隆類型: rabbit polyclonal
技術(shù)規(guī)格
|
Background: |
Cyclin-dependent kinases (CDKs) are a family of protein kinases first discovered for their role in regulating the cell cycle. They are also involved in regulating transcription, mRNA processing, and the differentiation of nerve cells. They are present in all known eukaryotes, and their regulatory function in the cell cycle has been evolutionarily conserved. CDKs are relatively small proteins, with molecular weights ranging from 34 to 40 kDa, and contain little more than the kinase domain. By definition, a CDK binds a regulatory protein called a cyclin. Without cyclin, CDK has little kinase activity; only the cyclin-CDK complex is an active kinase. CDKs phosphorylate their substrates on serines and threonines, so they are serine-threonine kinases. |
|
Applications: |
ELISA, IHC |
|
Name of antibody: |
CDK11A/CDK11B |
|
Immunogen: |
Synthetic peptide of human CDK11A/CDK11B |
|
Full name: |
cyclin-dependent kinase 11A/B |
|
Synonyms: |
CDC2L2; CDC2L3; p58GTA; PITSLRE; CDK11-p46; CDK11-p58; CDK11-p110 / p58; PK58; CDK11; CLK-1; CDC2L1; p58CLK-1; CDK11-p46; CDK11-p58; p58CDC2L1; CDK11-p110 |
|
SwissProt: |
B7ZVY7 |
|
ELISA Recommended dilution: |
1000-5000 |
|
IHC positive control: |
Human thyroid cancer and Human brain |
|
IHC Recommend dilution: |
50-200 |

 購物車
購物車 幫助
幫助
 021-54845833/15800441009
021-54845833/15800441009